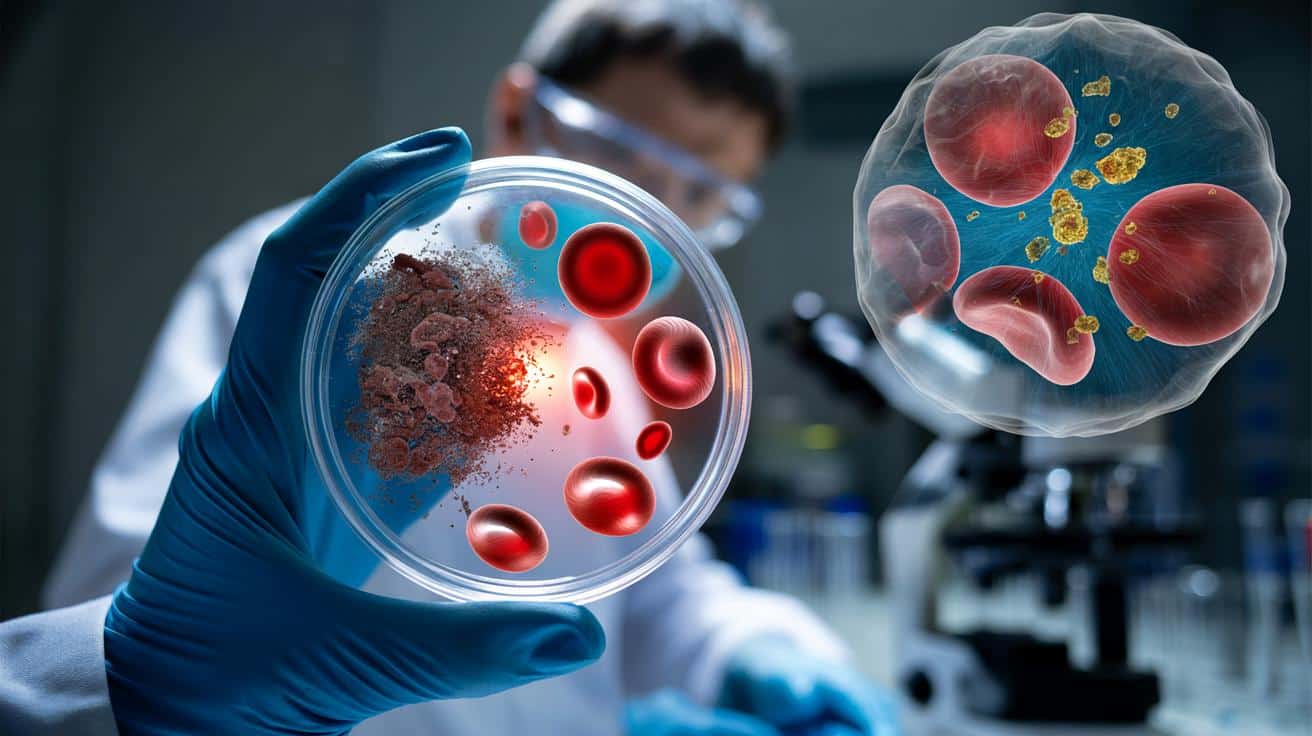
Naukowcy „odmładzają” stare komórki krwi. Przełom w walce ze starzeniem

Naukowcy „odmładzają” stare komórki krwi. Przełom w walce ze starzeniem
Wyobraź sobie, że Twój szpik kostny – ta fabryka produkująca krew przez całe życie – z wiekiem zaczyna szwankować. Komórki macierzyste tracą tempo, błędów przybywa, a układ odpornościowy przestaje nadążać. To właśnie dlatego po sześćdziesiątce jesteśmy bardziej podatni na infekcje i nowotwory krwi. Teraz naukowcy pokazują, że ten proces można częściowo odwrócić – i to nie na poziomie teorii, ale w konkretnych eksperymentach na żywych organizmach.
Najważniejsze informacje:
- Komórki macierzyste krwi produkują czerwone i białe krwinki oraz płytki – fundament odporności
- U osób po sześćdziesiątce układ odpornościowy staje się ospały i podatny na infekcje
- Lizosoomy w starych komórkach są rzadsze, nadmiernie zakwaszone i mniej efektywne
- Inhibitor ATPazy wakuolarnej przywraca młodzieńczy profil pracy lizosomów
- Po terapii potencjał odnowy komórek krwi wzrósł ponad ośmiokrotnie
- Hamowanie szlaku cGAS-STING zmniejsza przewlekły stan zapalny w komórkach
Międzynarodowy zespół badaczy pokazał, że stare komórki macierzyste krwi można częściowo „cofnąć w czasie” i przywrócić im sprawność.
Eksperyment wykonany na myszach sugeruje, że w przyszłości medycyna może nie tylko łagodzić skutki starzenia układu odpornościowego, ale realnie je odwracać, celując w konkretny mechanizm wewnątrz komórek.
Co właściwie udało się zrobić naukowcom
Praca opublikowana w czasopiśmie Cell Stem Cell opisuje badania nad komórkami macierzystymi krwi, czyli komórkami hematopoetycznymi. To one przez całe życie produkują czerwone krwinki, płytki oraz białe krwinki – fundament odporności.
U starszych organizmów te komórki działają znacznie gorzej: słabiej się odnawiają, częściej popełniają błędy, a układ odpornościowy staje się ospały i podatny na infekcje oraz nowotwory krwi. Zespół z Instytutu Imagine w Paryżu i ośrodka Mount Sinai w Nowym Jorku postanowił sprawdzić, czy da się ten proces odwrócić na poziomie jednej komórki.
Badacze pokazali, że odpowiednio modulując tzw. centra recyklingu w komórkach, można wielokrotnie zwiększyć zdolność starych komórek macierzystych do wytwarzania zdrowych komórek krwi.
Dlaczego krew starzeje się szybciej, niż myślimy
Starzenie krwi nie jest tylko abstrakcyjnym pojęciem z podręczników. To zjawisko, które każdy odczuwa po sześćdziesiątce: częstsze infekcje, gorsza odpowiedź na szczepienia, dłuższa rekonwalescencja po operacjach. Za kulisami stoi właśnie degradacja komórek macierzystych w szpiku kostnym.
Gdy te komórki tracą zdolność naprawy, przestają wytwarzać zrównoważony zestaw komórek krwi. Rośnie ryzyko anemii, zaburzeń krzepnięcia oraz chorób takich jak białaczki czy inne nowotwory hematologiczne. W praktyce oznacza to krótsze, a przede wszystkim mniej zdrowe życie.
Lizosomy – niedoceniany „zakład oczyszczania” w komórce
Kluczem w nowym badaniu okazały się lizosomy, czyli małe pęcherzyki wewnątrz każdej komórki. Działają jak zakład utylizacji odpadów: trawią zużyte białka, fragmenty błon, a nawet uszkodzone elementy mitochondriów, a odzyskane składniki zamieniają w energię.
W teorii brzmi to idealnie. W praktyce, w starych komórkach macierzystych krwi ten system zaczyna szwankować. Zespół naukowców, korzystając z zaawansowanych technik analizy pojedynczych komórek (single-cell), pokazał, że lizosomy u starych myszy są:
- rzadsze niż u młodych osobników,
- nadmiernie zakwaszone,
- rozregulowane i mniej efektywne.
Gdy lizosomy nie radzą sobie z „śmieciami”, w komórce zaczynają gromadzić się uszkodzone cząsteczki, w tym fragmenty DNA z mitochondriów. To uruchamia stan przewlekłego stanu zapalnego, który jeszcze bardziej przyspiesza starzenie i osłabia funkcję komórek macierzystych.
Jak „naprawiono” stare komórki macierzyste
Naukowcy postanowili zadziałać dokładnie w tym newralgicznym miejscu. Zastosowali specyficzny inhibitor białka nazywanego ATPazą wakuolarną. To enzym, który kontroluje zakwaszenie wewnątrz lizosomów.
Kiedy ten enzym działa zbyt intensywnie, lizosomy stają się nadmiernie kwaśne i tracą zdolność do sprawnego recyklingu. Zahamowanie jego aktywności pozwoliło „uspokoić” cały system i przywrócić bardziej młodzieńczy profil pracy lizosomów.
Po krótkim traktowaniu starych komórek macierzystych tym inhibitorem ich potencjał odnowy komórek krwi wzrósł ponad ośmiokrotnie po przeszczepieniu do organizmu myszy.
Kluczowe w tym projekcie było rygorystyczne podejście: wszystkie mechanizmy najpierw analizowano poza organizmem (ex vivo), a potem potwierdzano w żywych modelach zwierzęcych (in vivo). Dzięki temu autorzy badania mają mocniejsze podstawy, by sugerować przyszłe zastosowania terapeutyczne.
Zmniejszenie stanu zapalnego w komórce
Jednym z najbardziej interesujących efektów terapii było ograniczenie aktywności szlaku cGAS–STING. To wewnątrzkomórkowy system alarmowy, który reaguje na obecność nieprawidłowego DNA w cytoplazmie i uruchamia silną reakcję zapalną.
W starych komórkach macierzystych fragmenty mitochondrialnego DNA często trafiają tam, gdzie nie powinny, przez co system cGAS–STING pozostaje cały czas pobudzony. Po „usprawnieniu” pracy lizosomów komórki lepiej radziły sobie z utylizacją tego materiału, a poziom stanu zapalnego wyraźnie spadł.
Co z tego może wyniknąć dla medycyny
Choć badania przeprowadzono na myszach, scenariusze medyczne są bardzo konkretne. Naukowcy wymieniają kilka głównych kierunków, które w przyszłości mogą skorzystać na tym podejściu:
- leczenie zaburzeń krwi związanych z wiekiem, takich jak niektóre anemie i zespoły mielodysplastyczne,
- poprawa skuteczności przeszczepów szpiku kostnego u starszych pacjentów,
- wzmocnienie terapii genowych, które wymagają zdrowych, mocnych komórek macierzystych jako „nośnika” zmian genetycznych.
Terapia celująca w lizosomy mogłaby stać się rodzajem przygotowania lub „odmładzającego serwisu” dla komórek macierzystych pobranych od pacjenta przed ich wszczepieniem z powrotem do organizmu.
Międzynarodowa współpraca i zaawansowane technologie
Projekt był efektem współpracy laboratoriów specjalizujących się w dwóch uzupełniających się dziedzinach. Zespół z Mount Sinai wniósł dogłębną wiedzę z biologii komórek macierzystych, natomiast ośrodek Instytutu Imagine – doświadczenie w genomice pojedynczych komórek i analizach wielo-omicznych (łączenie danych genomowych, transkryptomicznych, proteomicznych itd.).
To połączenie pozwoliło spojrzeć na starzenie komórek macierzystych bardzo szczegółowo: osobno dla każdej komórki, zamiast uśredniać sygnał z dużych populacji. Dzięki temu dało się uchwycić subtelne zmiany, które uogólnione analizy zwykle gubią.
| Element badania | Rola w projekcie |
|---|---|
| Analiza pojedynczych komórek | Identyfikacja wadliwych lizosomów i stanów zapalnych w konkretnych komórkach macierzystych |
| Eksperymenty ex vivo | Testowanie inhibitora na izolowanych komórkach, precyzyjna kontrola dawki i czasu działania |
| Modele in vivo | Sprawdzenie, czy „odmłodzone” komórki naprawdę lepiej działają po przeszczepieniu do organizmu |
Czy to zapowiedź pigułki na odmładzanie?
Na tym etapie mowa głównie o terapii celowanej w komórki macierzyste w warunkach laboratoryjnych, a nie o tabletkach czy zastrzykach dla wszystkich seniorów. Każda próba ingerencji w tak podstawowy system jak lizosomy wymaga wyjątkowej ostrożności, bo te struktury występują w praktycznie wszystkich komórkach ciała.
Zbyt mocne lub niewłaściwe hamowanie ATPazy wakuolarnej mogłoby odbić się na innych tkankach, a nawet zwiększyć ryzyko niekontrolowanych podziałów komórkowych. Dlatego potencjalne terapie będą prawdopodobnie stosowane lokalnie – np. na pobrane komórki szpiku – zamiast działać na cały organizm naraz.
Co może się zmienić w praktyce klinicznej
Jeśli badania na myszach potwierdzą się w komórkach ludzkich, transplantolodzy i hematolodzy mogą zyskać nowe narzędzie. Proces mógłby wyglądać tak: lekarze pobierają komórki macierzyste szpiku od starszego pacjenta, „serwisują” je w laboratorium przy użyciu odpowiedniego inhibitora, a dopiero potem przeszczepiają z powrotem.
Taki zabieg mógłby poprawić jakość wszczepionych komórek, skrócić okres osłabionej odporności po przeszczepie i zmniejszyć ryzyko powikłań. Skorzystałyby na tym zwłaszcza osoby starsze leczone z powodu nowotworów krwi.
Co ta praca mówi o starzeniu jako procesie
Najciekawszy w całej historii jest sygnał, że starzenie komórek nie musi być liniową, nieodwracalną drogą w dół. Przynajmniej część zmian w komórkach macierzystych krwi wynika z rozregulowania konkretnych szlaków biologicznych, które da się modulować.
Nie oznacza to obietnicy nieśmiertelności czy całkowitego zatrzymania czasu. Raczej wskazuje, że medycyna przyszłości skupi się na utrzymaniu długotrwałej sprawności kluczowych tkanek – takich jak szpik kostny – zamiast tylko leczenia chorób, gdy już wybuchną.
Dla zwykłego pacjenta najważniejszy przekaz jest dość prosty: coraz lepiej rozumiemy, dlaczego wraz z wiekiem odporność siada i rośnie ryzyko nowotworów krwi. A skoro znamy przyczynę na poziomie komórki, rośnie szansa, że w kolejnych dekadach pojawią się terapie, które pozwolą zachować silny układ odpornościowy znacznie dłużej niż dziś.
Najczęściej zadawane pytania
Czy naukowcy faktycznie potrafią odmłodzić stare komórki krwi?
Tak, międzynarodowy zespół badawczy wykazał, że odpowiednio modulując lizosomy można przywrócić starym komórkom macierzystym krwi znacznie większą zdolność do produkcji zdrowych komórek krwi.
Jak działa ten mechanizm „odmładzania"?
Naukowcy zastosowali inhibitor ATPazy wakuolarnej, który kontroluje zakwaszenie lizosomów. Zahamowanie tego enzymu pozwala uspokoić system recyklingu w komórce i przywrócić mu sprawniejsze działanie.
Czy to oznacza, że wkrótce będzie dostępna pigułka na odmładzanie?
Na razie nie. Badania prowadzono na myszach, a potencjalne terapie będą prawdopodobnie stosowane lokalnie – na komórki pobrane od pacjenta przed przeszczepem szpiku, a nie na cały organizm.
Kto może skorzystać z tej terapii w przyszłości?
Osoby starsze z zaburzeniami krwi związanymi z wiekiem, pacjenci wymagający przeszczepu szpiku kostnego oraz osoby leczone z powodu nowotworów krwi.
Wnioski
Dla zwykłego pacjenta ta wiadomość oznacza rosnącą nadzieję. Choć miną jeszcze lata, zanim terapie dotrą do klinik, to właśnie basic research otwiera drzwi do przyszłości, w której starsi ludzie będą mogli zachować sprawny układ odpornościowy znacznie dłużej. Jeśli teraz masz ponad pięćdziesiątkę i obserwujesz u siebie gorszą odporność – wiedz, że nauka pracuje nad rozwiązaniem. Warto śledzić rozwój badań nad lizosomami, bo to może być jeden z najważniejszych przełomów medycznych najbliższej dekady.
Podsumowanie
Międzynarodowy zespół badaczy z Paryża i Nowego Jorku odkrył, że można częściowo cofnąć proces starzenia komórek macierzystych krwi. Poprzez oddziaływanie na lizosomy – komórkowe „fabryki recyklingu" – naukowcy zwiększyli ponad ośmiokrotnie zdolność regeneracyjną starych komórek. Badania na myszach pokazują, że w przyszłości będzie można leczyć zaburzenia krwi związane z wiekiem.